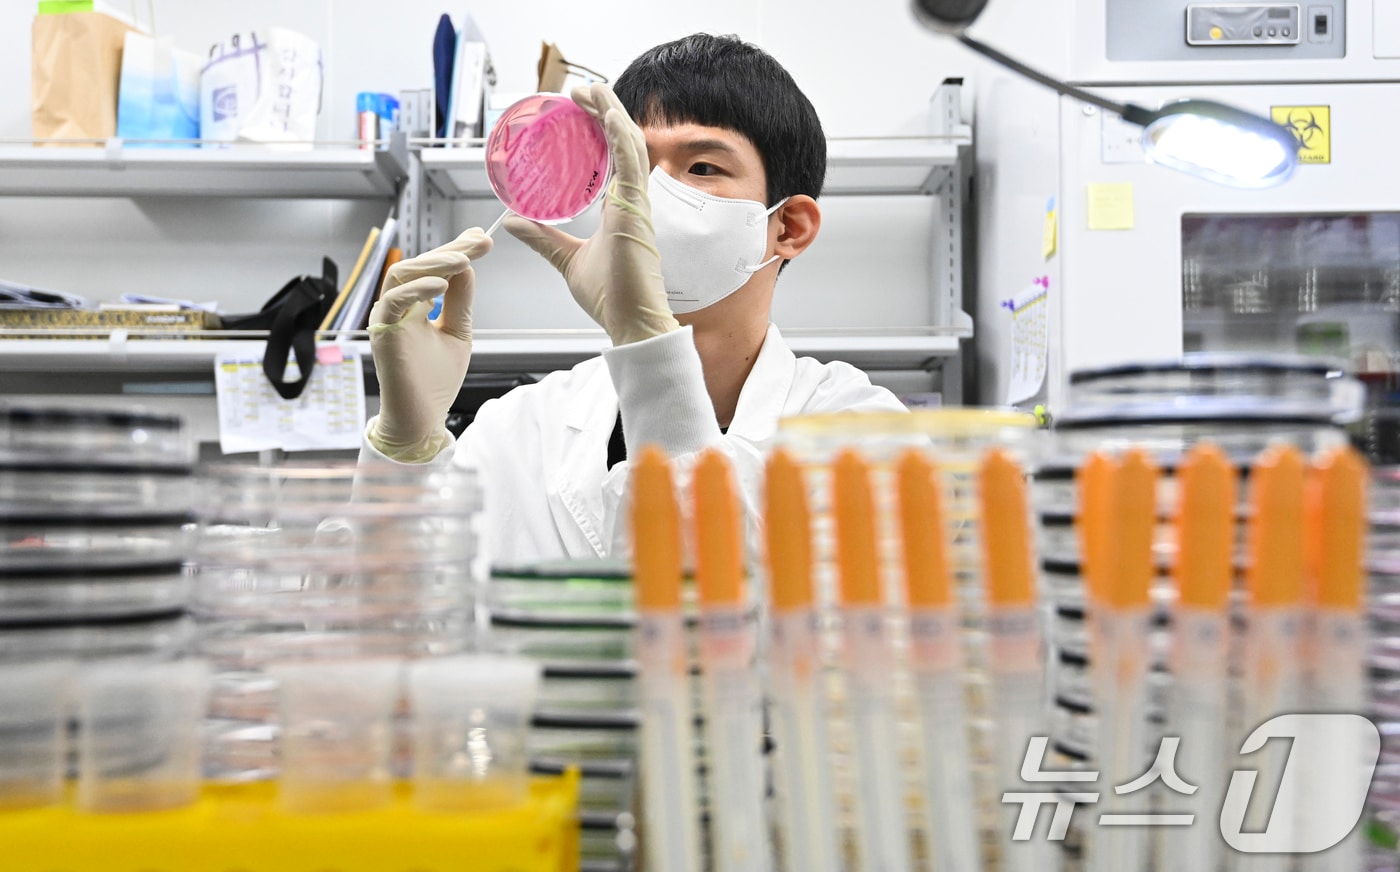
29일 오전 경기도 수원시 권선구 경기도보건환경연구원에서 감염병연구부 수인성질환팀 직원이 식중독균 배양검사를 하고 있다. (공동취재) 2024.8.29/뉴스1 ⓒ News1 이재명 기자

식약처, 어린이집 집단급식소 6200여 곳 '식중독 예방' 위생 점검
- 강승지 기자
(서울=뉴스1) 강승지 기자 = 식품의약품안전처는 어린이집 집단급식소 6200여 곳을 대상으로 다음달 7일부터 27일까지 지방자치단체와 함께 지도·점검을 실시한다고 24일 밝혔다.
이번 점검은 기온이 높아지는 여름철을 앞두고 식중독을 예방하기 위해 이뤄진다.
식약처는 소비기한 경과 제품 사용‧보관, 보존식 보관, 식품과 조리실 등 급식시설 위생관리 여부 등을 점검할 방침이다.
이와 함께 급식용 조리도구, 조리식품 등을 수거·검사해 식중독균 오염 여부도 확인한다.
아울러 점검 기간 대량 음식 조리 시 주의사항, 노로바이러스 환자 구토물 소독·처리 방법 등 식중독 예방 교육·홍보도 병행할 계획이다.
식약처는 "기온과 습도가 높아지는 계절에는 노로바이러스와 세균성 식중독이 많이 발생한다. 집단급식소는 위생관리를 철저히 하며, 식중독 예방 수칙을 실천해야 한다"고 당부했다.
한편, 식약처는 올해 전국 어린이집 집단급식소 1만 300여 곳을 모두 점검할 계획이다. 다음달 전체 어린이집의 약 60%를 점검하고 나머지 40%는 10월에 점검한다.
ksj@news1.kr
Copyright ⓒ 뉴스1. All rights reserved. 무단 전재 및 재배포, AI학습 이용금지.









